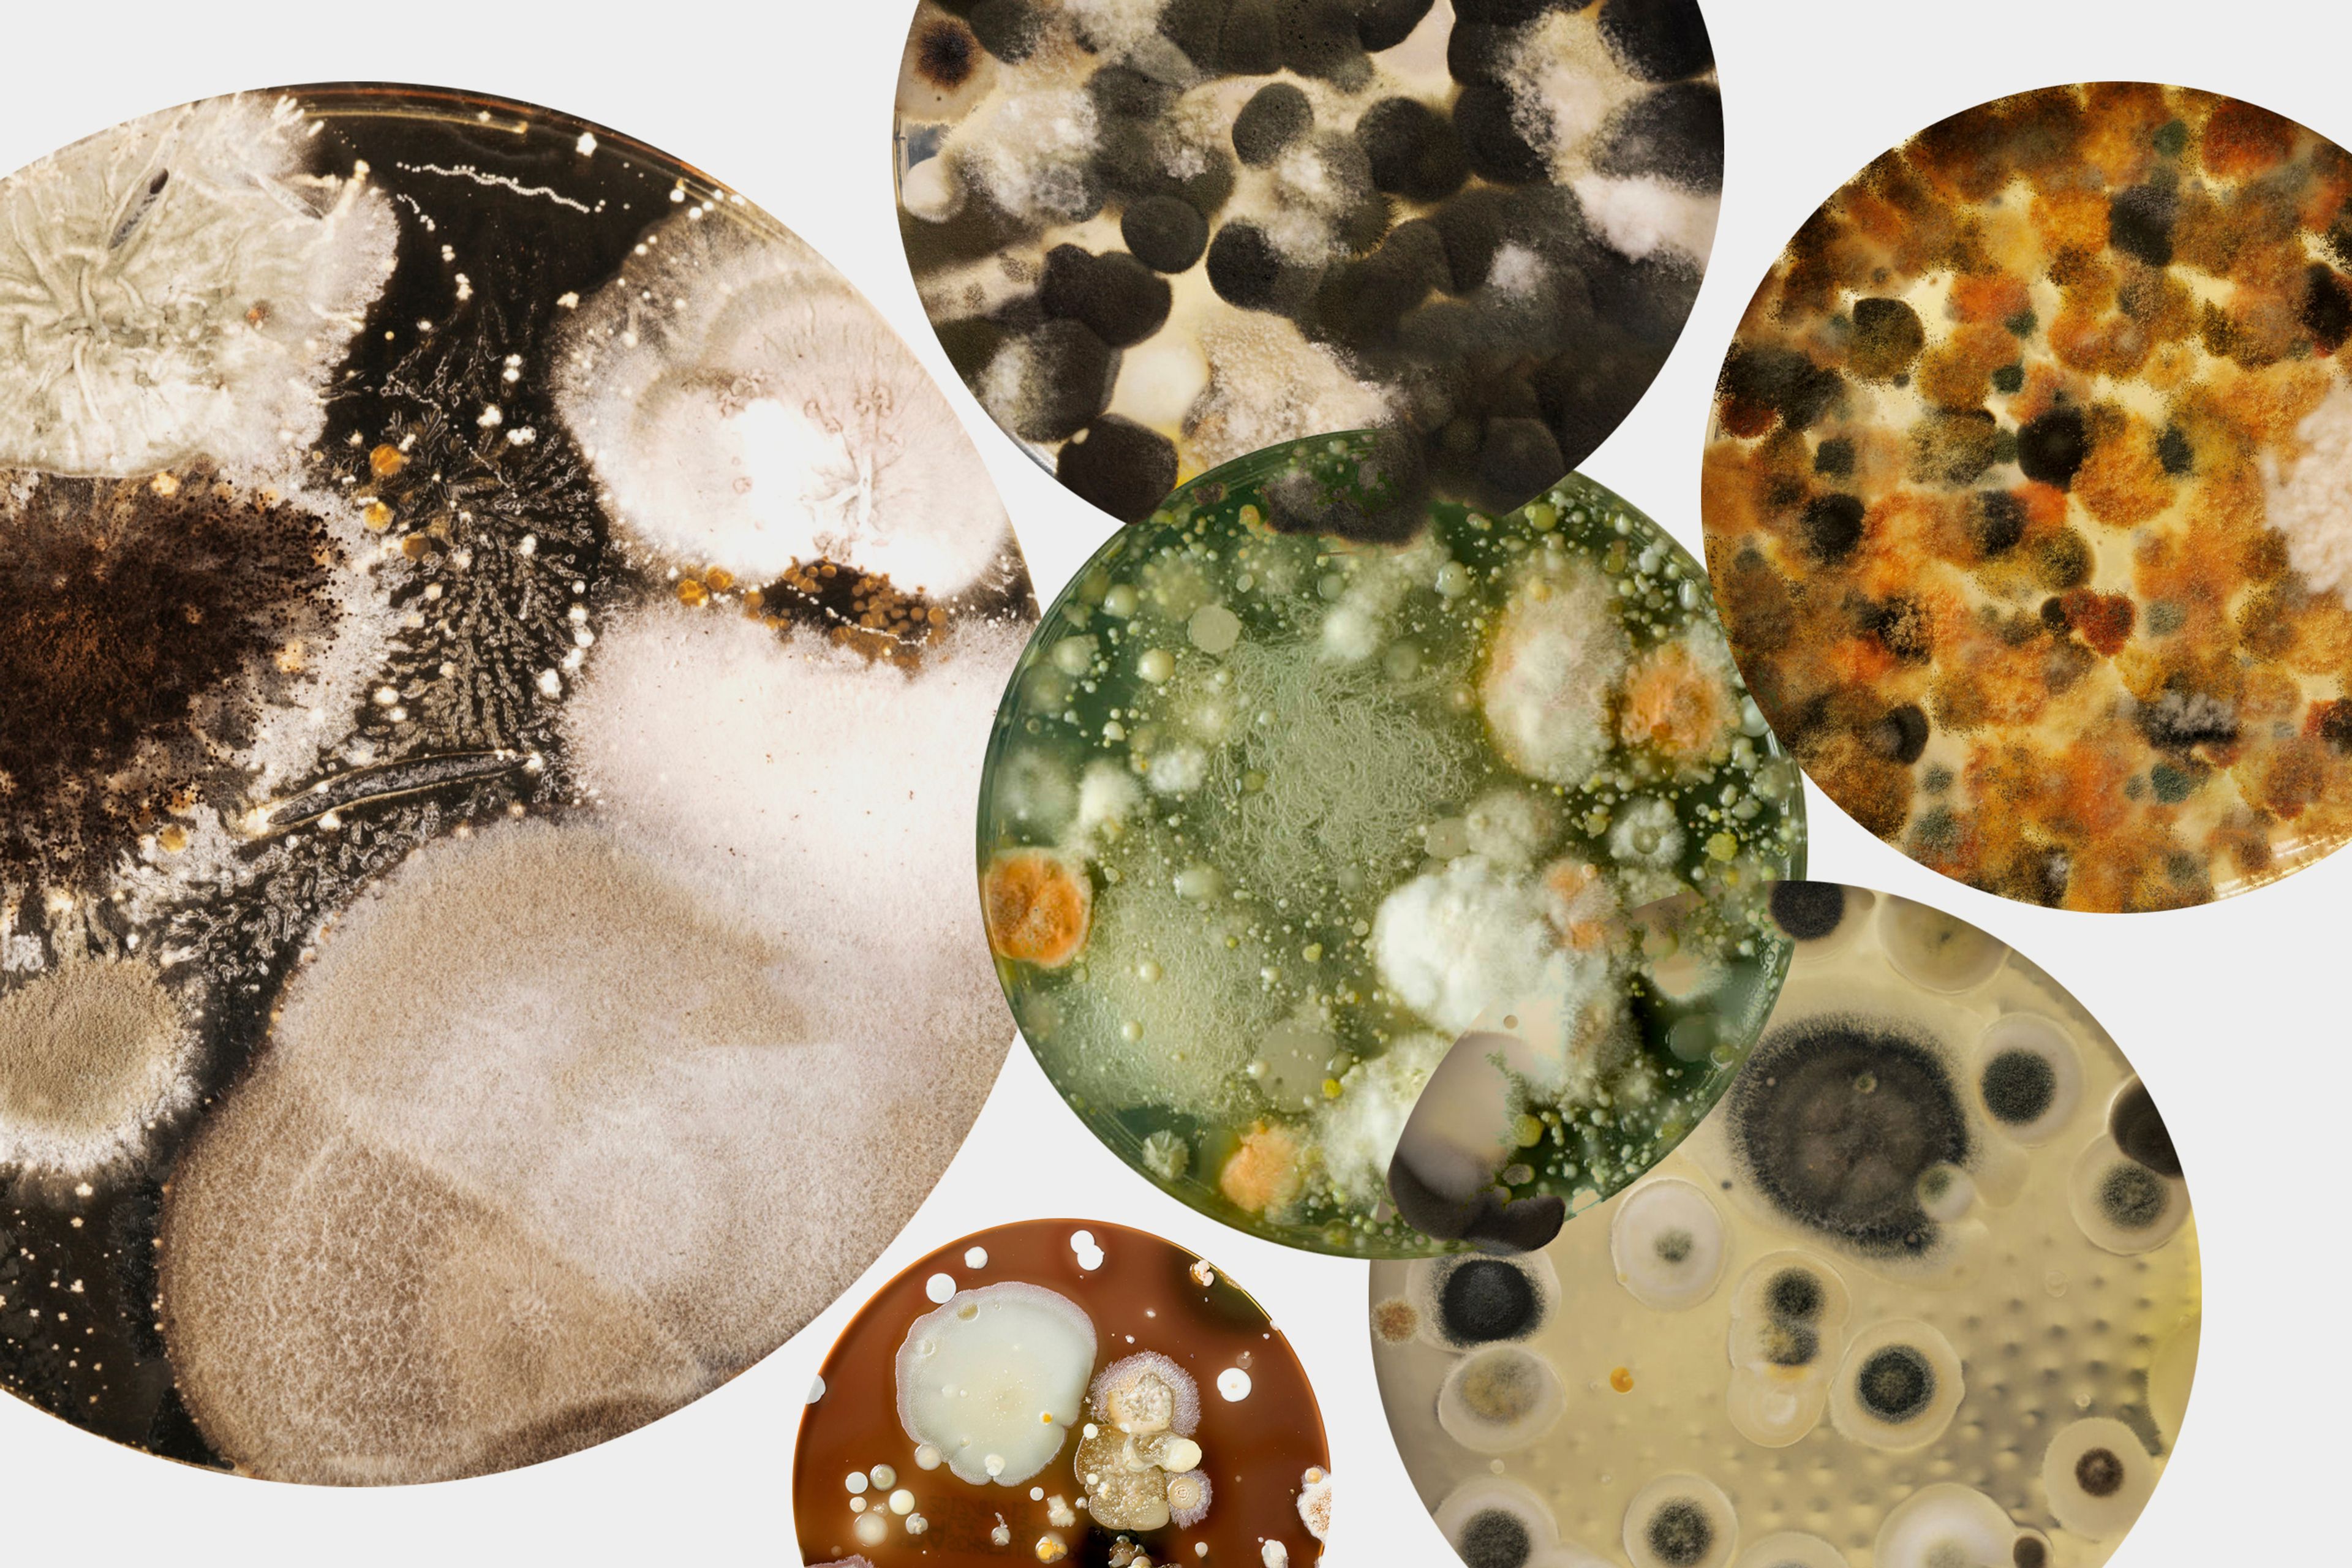
Collage of petri dishes with bacteria culture

New study shows few people produce enough Urolithin A
Unlocking a potent gut metabolite that most people can't get from diet alone. Mitopure is the first and only clinically test pure Urolithin A.

People have used the proverbial saying that “you are what you eat” to guide their choice of food and drink for decades. The phrase is backed by solid logic and evidence: our diet provides our bodies with the nutrients and vitamins we need to protect, maintain and sustain our bodies, mind, and overall health.
But is that always true? A fascinating new scientific study now shows that we are not always what we eat. In fact, the research shows, the nutrients available in some foods never actually make it into the systems of most people who eat them. That’s because they don’t have the right bacteria in their guts to digest and process them.
Take the pomegranate. Long-heralded as a symbol of fertility, the fruit has been reinvented recently as a so-called superfood. Salads, desserts, and cocktails now routinely feature the jewel-like pomegranate seeds and sales of pomegranate juice are booming. There’s a good reason for that. Pomegranates are packed with molecules called polyphenols, which act as antioxidants and are linked to heart and anti-cancer benefits.
The new research study, published in the European Journal of Clinical Nutrition, focuses on a type of polyphenol called ellagitannins. Common in nuts and berries as well as pomegranates, ellagitannins are especially useful as once eaten and digested, they can be converted in the body to a different molecule called Urolithin A.
A string of studies has shown that Urolithin A can act as a potent anti-aging agent. Specifically, it helps cells to replace worn-out components called mitochondria, which provide the body with energy. When muscles weaken as people age, it’s often because their mitochondria are no longer working properly. Research, including clinical studies in people, indicates that Urolithin A can slow and even reverse this deterioration.
That’s the good news. The bad news, the latest study reveals, is that the majority of people don’t have any Urolithin A in their systems. Tests on 100 volunteers in Chicago showed just 12 of them had detectable levels in their blood.
“We were really surprised by this finding. Given the importance of urolithin A to mitochondrial and cell health, we didn’t expect that so few healthy people across different ages would have enough. The others are really missing out.”Dr. Anurag Singh
Does this mean they were skimping on their strawberries and pomegranates? Not eating their walnuts? Not necessarily. The scientists next asked the volunteers to drink a glass of 100% pomegranate juice and checked their blood again for Urolithin A the following day. By now the bodies of the volunteers should have been flooded with all the ellagitannins they needed to make plenty of urolithin A. But even then, only 40% of them had a significant amount of the anti-aging molecule in their blood. The other 60% had none or very little – despite the glass of pomegranate juice just 24 hours earlier.
One hundred people is a small sample, but if the results were typical of the United States population, then the study suggests that more than half the population is unable to produce their own Urolithin A, however healthy and balanced their diet. And that means they are missing out on the health and anti-aging benefits. Unfortunately, these people are not what they eat.
What’s going on? To investigate, the scientists used genetic sequencing technology to analyze the DNA of microorganisms living in the guts of the volunteers. They looked at the number and variety of different strains and checked how these changed between the three groups: those people who produced no Urolithin A, those who produced a little, and those who produced a lot.
The results were striking: those volunteers able to convert the ellagitannins in the pomegranate juice into the most Urolithin A had richer and more diverse populations of microorganisms in their guts – a collective called their gut microbiome. About one hundred trillion of these microorganisms are thought to live in the average human gastro-intestinal tract. Most of these are bacteria, but there are also viruses, fungi, and simple, single-celled, organisms called protozoa.
Research on the gut microbiome is a new and expanding area. Scientists aren’t sure why some people host different microorganisms to others, but it could be down to genetics, diet, age, antibiotic use, and even how they were delivered as a baby.
Petri dishes with bacteria culture
In the new study, the scientists couldn’t identify which specific gut bacteria were involved in converting the ellagitannins into Urolithin A. But they found some clues. People who could produce Urolithin A had a greater proportion of a bacterial class called Firmicutes. Specifically, they had lots of bacteria from the Clostridiales and Ruminococcaceae families.
In time, researchers might find ways to encourage the growth of the right kind of gut bacteria, to help those who can’t currently produce Urolithin A to be able to do so. But until then, how can more people benefit from this natural anti-aging compound?
To find out, the study scientists carried out a final test. They gave the volunteers supplements that contain an extracted and purified form of Urolithin A. Called Timeline contains 500mg of Mitopure Urolithin A in a powder that was mixed into yogurt. Within a few hours of swallowing it, the levels of Urolithin A in all 100 volunteers had shot up – peaking at about six times as high as those who could produce the compound after they drank the pomegranate juice.
“These results show that a nutritious diet just isn’t enough. Without the right gut microbiome, people won’t get all the health benefits and that creates a huge gap in our current approaches. One solution is direct supplementation. It can solve the non-producer problem and help everyone to access these important anti-aging benefits.”Dr. Anurag Singh
In other words, while you aren’t always what you eat, a little help can get you there.

Pomegranate and Pineapple Smoothie with Mitopure
Authors

Written by
Editorial Staff

·
Nutrition·
Studies·
2025’s Breakthrough Findings on Urolithin A

·
Nutrition·
Studies·
New Study: Urolithin A Revitalizes an Aging Immune System

·
Nutrition·
Studies·









